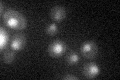
YCR014C
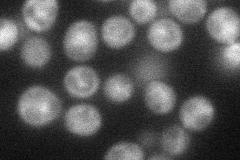
YCR014C
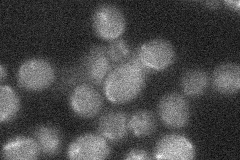
YCR014C

View description
DNA polymerase IV, undergoes pair-wise interactions with Dnl4p-Lif1p and Rad27p to mediate repair of DNA double-strand breaks by non-homologous end joining (NHEJ); homologous to mammalian DNA polymerase beta
Localization:
Intensity:
Fold change:
Significance:
-
C’ GFP library in SD
nucleus23.07 -
N' NOP1pr-GFP in SD
cytosol43.9684 -
N' TEF2pr-mCherry in SD

nucleus19.2639 -
N' NATIVEpr-GFP in SD
below threshold19.0715 -
N' TEF2pr-VC and Cyto-VN in SD

#N/A0 -
C’ GFP library in SD+DTT

nucleus23.81.03No -
C’ GFP library in SD+H2O2

nucleus25.241.09No -
C’ GFP library in Starvation Media

nucleus22.660.98No -
C’ GFP library on the background of Pup2-DaMP

nucleus -
C’ GFP library on the background of CCT mutant

nucleus27.1381.17602No
